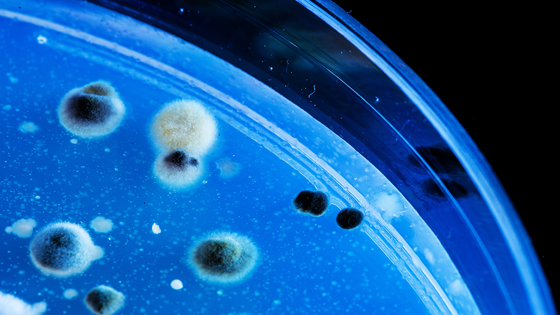

Создан препарат, заставляющий опасные бактерии разрушать собственную ДНК
Устойчивость некоторых видов болезнетворных бактерий к существующим антибиотикам повышается с каждым годом. Учёные из разных стран пытаются придумать универсальное лекарство, к которому бы бактерии не привыкали так быстро, но пока это никому не удалось. Однако некоторые исследования выглядят весьма многообещающе, например инновационная методика, разработанная специалистами Висконсинского университета в Мэдисоне. Если верить официальной статистике американского Центра по контролю заболеваний, то от одной только анаэробной бактерии Clostridium difficile ежегодно умирают более 15 000 человек. Эта бактерия признана одной из наиболее резистентных по отношению к антибиотикам и является возбудителем псевдомембранозного колита. Даже если подобрать наиболее эффективное сочетание антибиотиков, существует риск уничтожить большую часть микрофлоры кишечника, отчего больному станет только хуже. Именно поэтому сотрудник Висконсинского университета Ян-Питер ван Пийкерен создал некое подобие «пробиотического коктейля», который больной может употребить в виде жидкости или таблетки. Коктейль состоит из нескольких компонентов, наиболее важным из которых является специально подобранный и преобразованный бактериофаг. Инновационная терапия подразумевает использование технологии генного модифицирования бактериофагов и закладывания внутрь них своеобразного «послания» к определённому виду бактерий. Как только бактериофаг попадает в организм, он начинает охотиться на свою добычу, а при контакте с ней передаёт ей заложенную в него информацию. После чего бактерия начинает уничтожать свою собственную ДНК изнутри. Таким образом, учёный убил одним выстрелом сразу двух зайцев: он не затронул микрофлору кишечника, как это делают антибиотики, а также уничтожил бактерию точечным выстрелом. Пока исследование находится на ранних этапах, но учёный уже вот-вот приступит к тестированию своей методики на лабораторных животных.